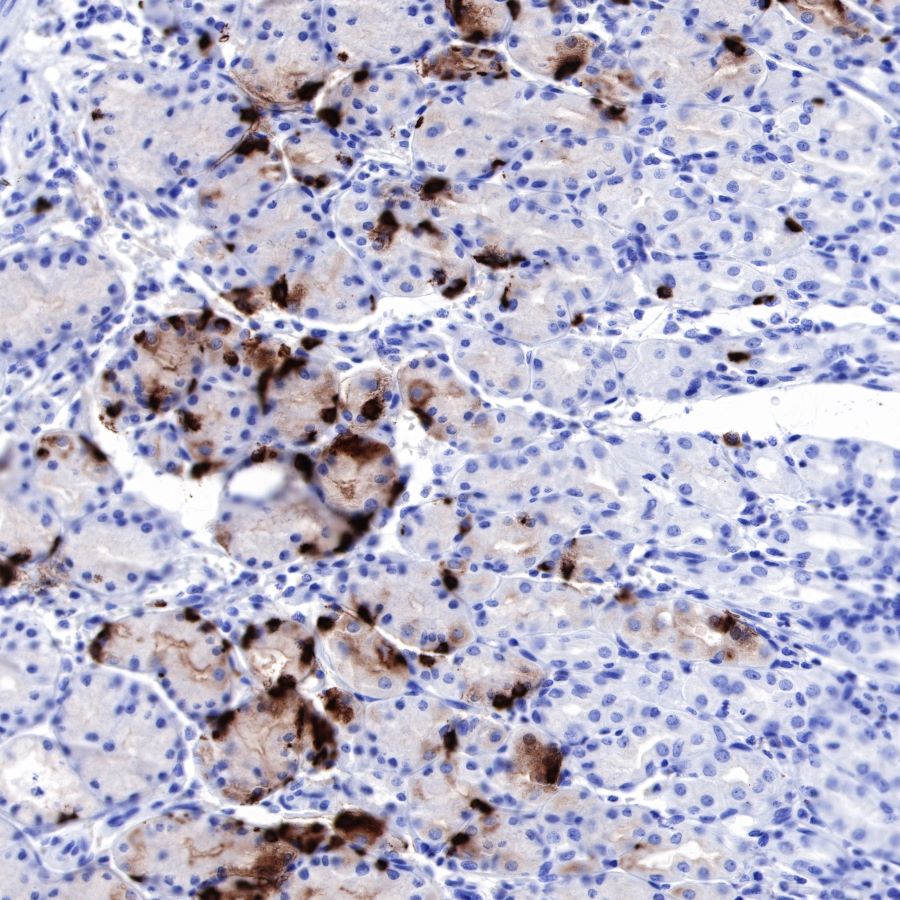

Product Specification
| Host |
Rabbit |
| Antigen |
Chromogranin A |
| Synonyms |
CHGA, Pituitary secretory protein I (SP-I) |
| Immunogen |
N/A |
| Location |
Secreted |
| Accession |
P10645 |
| Clone Number |
SDT-R042 |
| Antibody Type |
Rabbit mAb |
| Application |
WB, IHC-P |
| Reactivity |
Hu, Ms, Rt |
| Purification |
Protein A |
| Concentration |
0.25 mg/ml |
| Conjugation |
Unconjugated |
| Physical Appearance |
Liquid |
| Storage Buffer |
PBS, 40% Glycerol, 0.05%BSA, 0.03% Proclin 300 |
| Stability & Storage |
12 months from date of receipt / reconstitution, -20 °C as supplied |
Dilution
| application |
dilution |
species |
| WB |
1:500 |
|
| IHC-P |
1:1000 |
|
Background
Chromogranin A or parathyroid secretory protein 1 (gene name CHGA) is a member of the granin family of neuroendocrine secretory proteins. As such, it is located in secretory vesicles of neurons and endocrine cells such as islet beta cell secretory granules in the pancreas. In humans, chromogranin A protein is encoded by the CHGA gene. Chromogranin A is the precursor to several functional peptides including vasostatin-1, vasostatin-2,pancreastatin, catestatin and parastatin. These peptides negatively modulate the neuroendocrine function of the releasing cell (autocrine) or nearby cells (paracrine). Chromogranin A induces and promotes the generation of secretory granules such as those containing insulin in pancreatic islet beta cells. Chromogranin A is elevated in pheochromocytomas. It is used as an indicator for pancreas and prostate cancer and in carcinoid syndrome. It might play a role in early neoplasic progression. Chromogranin A is cleaved by an endogenous prohormone convertase to produce several peptide fragments. In immunohistochemistry it can be used to identify a range of neuroendocrine tumours and is highly specific for both benign and malignant cells of this type.